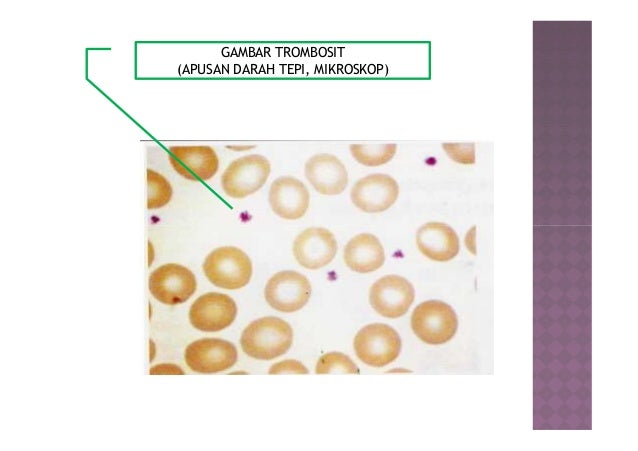

Ukuran normal margin, ukuran normal poster, ukuran normal gula darah, ukuran normal foto dalam inchi, ukuran normal kornea dan lensa mata manusia,

Random Image

Ukuran panjang tenis meja, ukuran panjang meja tenis meja friendship, ukuran panjang meja tenis meja butterfly, ukuran panjang meja tenis meja kettler, ukuran panjang meja tenis meja, ukuran meja, ukuran meja ping pong, ukuran meja tenis meja, ukuran meja makan, ukuran meja belajar, ukuran meja kantor, ukuran meja dapur, ukuran meja kerja, ukuran meja prasmanan, ukuran meja kasir, satuan ukuran panjang, tangga ukuran panjang, ukuran panjang lapangan sepak bola, urutan ukuran panjang, ukuran panjang shock belakang motor, ukuran panjang tongkat pramuka, ukuran panjang mobil sedan, ukuran panjang besi beton, pengiraan ukuran panjang, ukuran panjang spandek,



![Yuk! Ketahui Peraturan Tenis Meja Terbaru 2019 [Lengkap] Yuk! Ketahui Peraturan Tenis Meja Terbaru 2019 [Lengkap]](https://i1.wp.com/berolahraga.net/wp-content/uploads/2017/10/net-tenis.jpg?resize=720%2C468)








Random Image

Ukuran speaker 15 in, ukuran speaker hrv, ukuran speaker front door hrv,
Random Image

Ukuran kartu panitia, ukuran kartu pelajar, ukuran kartu nama, ukuran kartu, ukuran kartu atm, ukuran kartu remi, ukuran kartu ktp, ukuran kartu bpjs, ukuran kartu utbk, ukuran kartu kredit, ukuran kartu ucapan, ukuran kartu panitia, ukuran kartu pelajar, ukuran kartu souvenir, ukuran kartu undangan, ukuran kartu nama cm, ukuran kartu id card, ukuran kartu nama indonesia, ukuran kartu nama photoshop, ukuran kartu bpjs kesehatan, ukuran kartu undangan pernikahan,
Random Image

Perbedaan ukuran lapangan sepak bola nasional dana, perbedaan ukuran lapangan sepak bola nasional dance, perbedaan ukuran lapangan sepak bola nasional danica, perbedaan ukuran lapangan sepak bola nasional daniela, perbedaan ukuran lapangan sepak bola nasional daniel, perbedaan ukuran lapangan sepak bola nasional dank, perbedaan ukuran lapangan sepak bola nasional fm, perbedaan ukuran lapangan sepak bola nasionalisme, perbedaan ukuran lapangan sepak bola nasionale, perbedaan ukuran lapangan sepak bola national geographic, perbedaan ukuran lapangan sepak takrau, perbedaan ukuran lapangan futsal, perbedaan ukuran lapangan bola, perbedaan ukuran lapangan voli, perbedaan ukuran lapangan softball, perbedaan ukuran lapangan basket, perbedaan ukuran lapangan bulutangkis, perbedaan ukuran lapangan tenis, perbedaan ukuran kertas a4 dan a3, perbedaan ukuran iphone 6 dengan iphone 6, perbedaan ukuran pas foto, perbedaan ukuran payudara, perbedaan ukuran dna dan rna, perbedaan ukuran iphone 6 dan 6s, perbedaan ukuran iphone 6 plus dan iphone 7,







Random Image

Berapa ukuran foto polaroid, berapa ukuran foto selfi di bei, ukuran foto 2r berapa cm, berapa ukuran foto polaroid, ukuran foto 4r berapa cm, ukuran foto postcard berapa cm, foto ukuran 4x6 berapa pixel, foto ukuran 10r berapa cm, berapa ukuran foto selfi di bei, berapa ukuran kertas f4, berapa ukuran kertas a3, berapa ukuran foto polaroid, berapa ukuran bra dua semangka, berapa ukuran sensor kamera dslr, berapa ukuran screen ratio standard prezi, berapa ukuran foto selfi di bei, berapa ukuran balok untuk bentang 7 m,













Random Image

Blog Archive
-
▼
2019
(6130)
-
▼
July
(401)
- Ukuran Normal Trombosit Darah
- Ukuran Panjang Meja Tenis Meja
- Ukuran Speaker Pintu Calya
- Ukuran Kartu Pada Oppo A37
- Perbedaan Ukuran Lapangan Sepak Bola Nasional Dan ...
- Berapa Ukuran Foto 2 X 3
- Ukuran Berat Timbangan
- Harga Meja Belajar Cowok
- Ukuran Banner Tegak
- Website Compress Ukuran Foto
- Ukuran Xs Pull And Bear
- Ukuran Velg Avanza Veloz 2013
- Ukuran Velg Avanza Standar
- Perbandingan Ukuran Sepatu Indonesia Dan China
- Ukuran Kartu Nama
- Ukuran Kaki Paling Besar
- Ukuran Rangka Spring Bed
- Ukuran Tv Yang Ada
- Berapa Ukuran Hp Xiaomi 4a
- Maksud Ukuran Payudara A B C
- Ukuran Perusahaan Kecil
- Ukuran Normal Warna Tv
- Ukuran Garasi Mobil Untuk 2 Mobil
- Ukuran Notebook Asus X200m
- Ukuran Sepatu Yang Biasa Digunakan Di Indonesia
- Ukuran Perusahaan Pengertian
- Ukuran Baju Wanita Nomor
- Ukuran Venti Starbucks Berapa Ml
- Gambar Dan Ukuran Lapangan Bola Basket Yang Benar ...
- Ukuran Jari Jari Untuk Motor Vixion
- Ukuran Kertas Hvs Letter
- Ukuran Koper Bagasi Kabin Scoot
- Ukuran Tapak Velg Motor
- Ukuran Postcard Standar
- Ukuran Jari Jari Motor Jupiter Z Belakang
- Ukuran Lapangan Sepak Bola Yang Standar
- Ukuran Atap Baja Ringan Per Lembar
- Ukuran Snapgram Ig
- Harga Meja Makan Jati Antik
- Ukuran Lapangan Basket Minimal
- Ukuran Banner Channel Youtube
- Gambar Dan Ukuran Lemari Pakaian
- Ukuran Foto 20r Dalam Centimeter
- Harga Bata Ringan Di Garut
- Ukuran Standar Mini X-banner
- Ukuran Rantai Kawasaki Edge
- Ukuran Cincin Untuk Jari Wanita
- Ukuran Meja Kerja Kecil
- Ukuran Koper Yg Muat Di Kabin Pesawat
- Ukuran Label Undangan Yang Biasa Digunakan
- Ukuran Sepatu Us Uk Eu
- Tekanan Darah Tinggi Ciri
- Ukuran Rantai Win
- Harga Besi Siku Ukuran 50x50
- Ukuran Layar Hp Xiaomi Redmi 2
- Ukuran Asbes Terpendek
- Ukuran Poster Berapa R
- Ukuran Ban Mobil Yang Cocok Untuk R15
- Ukuran A4 In Cm
- Ukuran Layar Hp E63
- Ukuran Lingkar Dada Internasional
- Ukuran Meter Lapangan
- Ukuran Sepatu New Balance Wanita
- Ukuran Laptop Asus X452e
- Ukuran Lift Servis
- Ukuran Batako Standar
- Ukuran Video Di After Effect
- Ukuran Perusahaan Dalam Audit Delay
- Berapa Ukuran Lapangan Sepak Bola Lebar Gawang Dan...
- Harga Ubin Ukuran
- Ukuran Opening Jendela
- Ukuran Pin Piston Fizr
- Tuliskan Ukuran Tenis Meja
- Ukuran Gambar History Instagram
- Ukuran Lapangan Bola Voli Basket Sepakbola
- Ukuran Margin Dalam Pembuatan Skripsi
- Ukuran Lapangan Pemain Bola Voli Adalah
- Ukuran Ban Motor Dunlop
- Ukuran Tangga Rumah Bertingkat
- Harga Meja Tenis Meja Lipat
- Ukuran Foto E Ktp
- Pola Dan Ukuran Gamis Anak
- Ukuran Sim Card Iphone 6
- Cara Mengubah Ukuran Video Youtube
- Berapa Ukuran Panjang Janin 3 Bulan
- Tekanan Darah Tinggi Pasca Caesar
- Ukuran Panjang Pipa Pvc 3 Inch
- Ukuran Label Undangan 103 Dalam Inci
- Model Dapur Minimalis Ukuran 3x3
- Menentukan Ukuran Exhaust Fan
- Ukuran Baja Ringan Untuk Genteng
- Ukuran Terpal Besar
- Pengertian Ukuran Dispersi
- Ukuran Tilam Queen
- Harga Makan Meja Restoran Central
- Ukuran F4 Legal Atau Letter
- Tekanan Darah Normal Kisaran Berapa
- Tekanan Darah Normal Saat Melahirkan
- Ukuran Hp A3 2016
- Ukuran Banner Aqiqah
-
▼
July
(401)